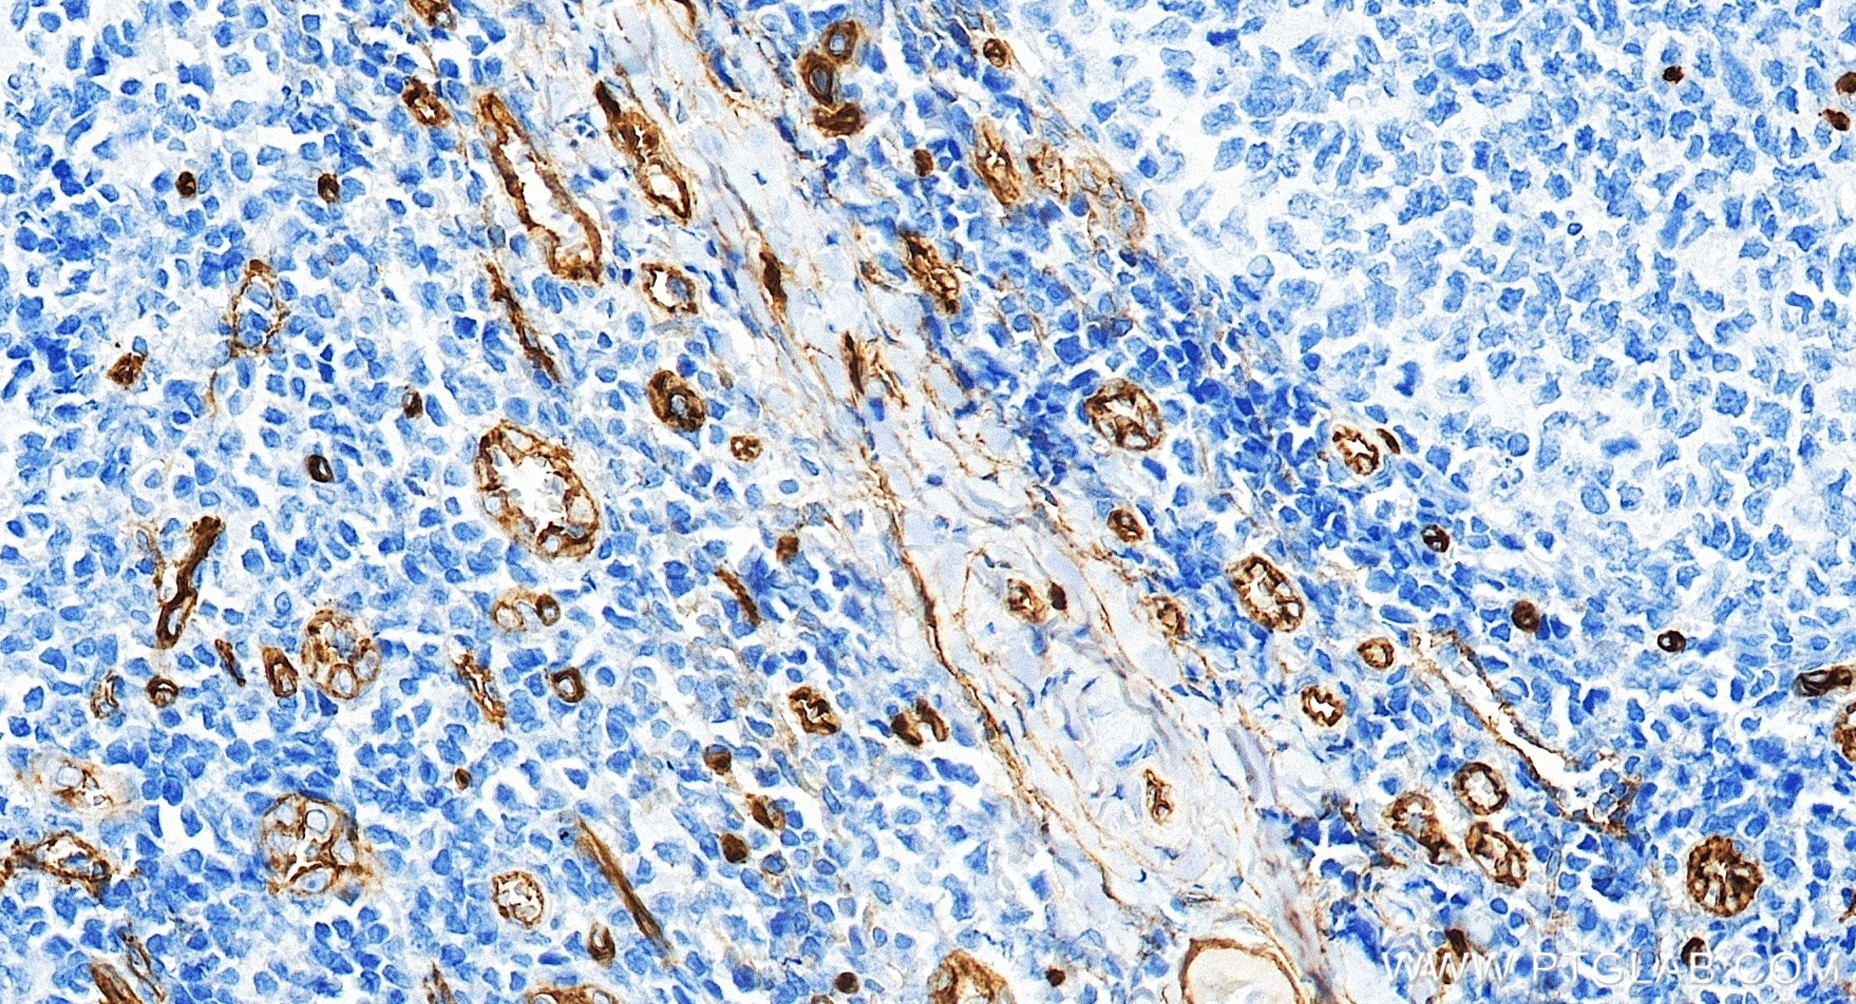
Immunohistochemical analysis of paraffin-embedded human tonsillitis tissue slide using 84242-5-RR (CD34 antibody) at dilution of 1:1000 (under 20x lens). Heat mediated antigen retrieval with Tris-EDTA buffer (pH 9.0). Immunohistochemistry (IHC) staining of human tonsillitis tissue using CD34 Recombinant monoclonal antibody (84242-5-RR)

Tested Applications
| Positive WB detected in | HL-60 cells, bEnd.3 cells, HUVEC cells, mouse testis tissue, human placenta tissue |
| Positive IHC detected in | human tonsillitis tissue, human colon cancer tissue, human liver cancer tissue, human placenta tissue Note: suggested antigen retrieval with TE buffer pH 9.0; (*) Alternatively, antigen retrieval may be performed with citrate buffer pH 6.0 |
| Positive IF-P detected in | human placenta tissue |
Recommended dilution
| Application | Dilution |
|---|---|
| Western Blot (WB) | WB : 1:1000-1:8000 |
| Immunohistochemistry (IHC) | IHC : 1:500-1:2000 |
| Immunofluorescence (IF)-P | IF-P : 1:50-1:500 |
| It is recommended that this reagent should be titrated in each testing system to obtain optimal results. | |
| Sample-dependent, Check data in validation data gallery. | |
Product Information
84242-5-RR targets CD34 in WB, IHC, IF-P, ELISA applications and shows reactivity with human samples.
| Tested Reactivity | human |
| Host / Isotype | Rabbit / IgG |
| Class | Recombinant |
| Type | Antibody |
| Immunogen |
Recombinant protein Predict reactive species |
| Full Name | CD34 molecule |
| Calculated Molecular Weight | 41 kDa |
| Observed Molecular Weight | 105 kDa |
| GenBank Accession Number | BC039146 |
| Gene Symbol | CD34 |
| Gene ID (NCBI) | 947 |
| Conjugate | Unconjugated |
| Form | Liquid |
| Purification Method | Protein A purfication |
| UNIPROT ID | P28906 |
| Storage Buffer | PBS with 0.02% sodium azide and 50% glycerol, pH 7.3. |
| Storage Conditions | Store at -20°C. Stable for one year after shipment. Aliquoting is unnecessary for -20oC storage. 20ul sizes contain 0.1% BSA. |
Background Information
CD34 is a 105- to 120-kDa glycophosphoprotein expressed on the majority of hematopoietic stem/progenitor cells, bone marrow stromal cells, capillary endothelial cells, embryonic fibroblasts, and some nerve tissue. CD34 is a commonly used marker for identifying human hematopoietic stem/progenitor cells and mediates cell adhesion and lymphocyte homing by binding L-selectin and E-selectin ligands. CD34 is also one of the best negative selection markers for characterizing and/or isolating human MSCs from bone marrow and other sources. Along with other positive selection markers (such as CD29, CD44, CD90, CD105 and CD166), negative selection markers (such as CD34 and CD45) are used for MSC identification.
Protocols
| Product Specific Protocols | |
|---|---|
| IF protocol for CD34 antibody 84242-5-RR | Download protocol |
| IHC protocol for CD34 antibody 84242-5-RR | Download protocol |
| WB protocol for CD34 antibody 84242-5-RR | Download protocol |
| Standard Protocols | |
|---|---|
| Click here to view our Standard Protocols |